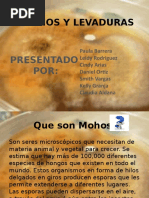

100% encontró este documento útil (1 voto)
508 vistas22 páginasTécnicas Inmunológicas Esenciales
Las técnicas inmunológicas permiten detectar y cuantificar antígenos y anticuerpos mediante tres métodos principales: 1) técnicas de aglutinación que detectan la unión antígeno-anticuerpo por aglutinación celular o bacteriana; 2) citometría de flujo y técnicas de inmunofluorescencia que detectan la fluorescencia emitida por la unión; y 3) radioinmunoensayos y ensayos de inmunoadsorción enzimática (ELISA) que permiten cuantificar la unión mediante
Cargado por
Anthony Jimmy Murillo JaimeDerechos de autor
© © All Rights Reserved
Nos tomamos en serio los derechos de los contenidos. Si sospechas que se trata de tu contenido, reclámalo aquí.
Formatos disponibles
Descarga como PPTX, PDF, TXT o lee en línea desde Scribd
100% encontró este documento útil (1 voto)
508 vistas22 páginasTécnicas Inmunológicas Esenciales
Las técnicas inmunológicas permiten detectar y cuantificar antígenos y anticuerpos mediante tres métodos principales: 1) técnicas de aglutinación que detectan la unión antígeno-anticuerpo por aglutinación celular o bacteriana; 2) citometría de flujo y técnicas de inmunofluorescencia que detectan la fluorescencia emitida por la unión; y 3) radioinmunoensayos y ensayos de inmunoadsorción enzimática (ELISA) que permiten cuantificar la unión mediante
Cargado por
Anthony Jimmy Murillo JaimeDerechos de autor
© © All Rights Reserved
Nos tomamos en serio los derechos de los contenidos. Si sospechas que se trata de tu contenido, reclámalo aquí.
Formatos disponibles
Descarga como PPTX, PDF, TXT o lee en línea desde Scribd